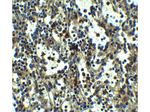
TLR3 Antibody in Immunohistochemistry (Paraffin) (IHC (P))

Search
Rockland
TLR3 Polyclonal Antibody
{{$productOrderCtrl.translations['antibody.pdp.commerceCard.promotion.promotions']}}
{{$productOrderCtrl.translations['antibody.pdp.commerceCard.promotion.viewpromo']}}
{{$productOrderCtrl.translations['antibody.pdp.commerceCard.promotion.promocode']}}: {{promo.promoCode}} {{promo.promoTitle}} {{promo.promoDescription}}. {{$productOrderCtrl.translations['antibody.pdp.commerceCard.promotion.learnmore']}}
产品信息
600-401-H26
种属反应
宿主/亚型
分类
类型
抗原
偶联物
形式
浓度
规格
纯化类型
保存液
内含物
保存条件
运输条件
靶标信息
TLR3 (Toll-like receptor 3, CD283) is a member of the Toll-like receptor (TLR) family which plays a fundamental role in pathogen recognition and activation of innate immunity. TLRs are highly conserved from drosophila to humans and share structural and functional similarities. TLRs recognize pathogen-associated molecular patterns (PAMPs) that are expressed on infectious agents, and mediate the production of cytokines necessary for the development of effective immunity. The various TLRs exhibit different patterns of expression. TLR3 is most abundantly expressed in placenta and pancreas, and is restricted to the dendritic subpopulation of the leukocytes. TLR3 recognizes dsRNA associated with viral infection, and induces the activation of NF-kappaB and the production of type I interferons. Further, TLR3 may play a role in host defense against viruses, and the use of alternative polyadenylation sites to generate different length transcripts has been noted for the TLR3 gene. Like its counterparts in Drosophila, TLRs signal through adaptor molecules and could constitute an important and unrecognized component of innate immunity in humans. The TLR family is a phylogenetically conserved mediator of innate immunity that is essential for microbial recognition. TLRs characterized so far activate the MyD88/interleukin-1 receptor-associated kinase (IRAK) signaling pathway. TLR3 is the only human TLR which does not utilize MyD88 as an adaptor molecule instead utilizing TRIF in a signaling path which results in downstream activation of IRF-3 and NF-kB. TLR3 activation leads not only to Type I interferon induction but also to other inflammatory cytokines which result in DC maturation. TLR3 is known to recognize viral double-stranded (ds) RNA, a molecular pattern associated with viral infection. Recently it has been shown to recognize viruses such as Influenza A and West Nile Virus and can mediate entry of at least West Nile Virus.
仅用于科研。不用于诊断过程。未经明确授权不得转售。
篇参考文献 (0)
生物信息学
蛋白别名: CD283; TLR 3; TLR3; Toll-like receptor 3; unnamed protein product
基因别名: AI957183; CD283; IIAE2; IMD83; TLR3
UniProt ID: (Human) O15455, (Mouse) Q99MB1
Entrez Gene ID: (Human) 7098, (Mouse) 142980